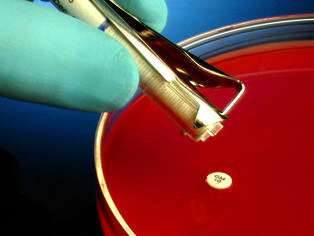

Cefaclor Cec-30 For Suspct Tstg 1x50disk, Pack Of 50
$ 15.66
|
|
Details:
Cefaclor CEC-30 HardyDisks* AST 1x50 disk^ Cefaclor, CEC-30, HardyDisks*, for susceptibility testing, impregnated paper disks used for Antimicrobial Susceptibility Testing (AST), also known as disk diffusion or Kirby-Bauer testing, The last disk in each cartridge is clearly marked, Size: 1x50disks
Additional Information
| SKU | 23999588 |
|---|---|
| UOM | Pack of 50 |
| UNSPSC | 41104118 |
| Manufacturer Part Number | Z8121 |
| Product Dimensions | 4X4X8 Inches |
| Product Weight | 0.1 |
